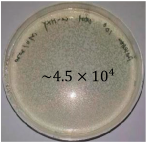
Inventions 10 00018 i001
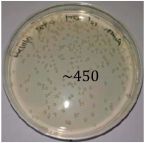
Inventions 10 00018 i003
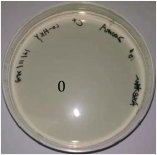
Inventions 10 00018 i004
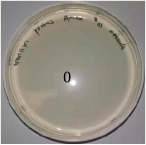
Inventions 10 00018 i006

An Efficient Contamination-Reducing Closet for Reusing Protective Clothing
Abstract
1. Introduction
2. Materials and Methods
2.1. Implementation and Specifications of a Disinfection Module
2.2. Working Current Selection
2.3. Irradiance Characterization
2.4. Disinfection Efficiency Characterization
2.5. Implementation and Specifications of the Disinfection Closet
3. Results
3.1. Thermal Test
3.2. Irradiance Test
3.3. Protective Clothing Filtration Efficiency Characterization
4. Limitations
5. Conclusions
Supplementary Materials
Author Contributions
Funding
Data Availability Statement
Conflicts of Interest
References
- Karim, N.; Afroj, S.; Lloyd, K.; Oaten, L.C.; Andreeva, D.V.; Carr, C.; Farmery, A.D.; Kim, I.D.; Novoselov, K.S. Sustainable personal protective clothing for healthcare applications: A review. ACS Nano 2020, 14, 12313–12340. [Google Scholar] [CrossRef] [PubMed]
- Kasatpibal, N.; Whitney, J.D.; Katechanok, S.; Ngamsakulrat, S.; Malairungsakul, B.; Sirikulsathean, P.; Nuntawinit, C.; Muangnart, T. Prevalence and risk factors of needlestick injuries, sharps injuries, and blood and body fluid exposures among operating room nurses in Thailand. Am. J. Infect. Control. 2016, 44, 85–90. [Google Scholar] [CrossRef] [PubMed]
- Ha, J.F. The COVID-19 pandemic and face shields. J. Br. Surg. 2020, 107, 398. [Google Scholar] [CrossRef] [PubMed]
- Khan, M.T.; Shah, I.A.; Hossain, M.F.; Akther, N.; Zhou, Y.; Khan, M.S.; Al-Shaeli, M.; Bacha, M.S.; Ihsanullah, I. Personal protective equipment (PPE) disposal during COVID-19: An emerging source of microplastic and microfiber pollution in the environment. Sci. Total Environ. 2023, 860, 160322. [Google Scholar] [CrossRef]
- Islam, S.D.; Safiq, M.B.; Bodrud-Doza, M.; Mamun, M.A. Perception and attitudes toward PPE-related waste disposal amid COVID-19 in Bangladesh: An exploratory study. Front. Public Health 2020, 8, 592345. [Google Scholar] [CrossRef]
- Yang, J.H.; Wu, U.I.; Tai, H.M.; Sheng, W.H. Effectiveness of an ultraviolet-C disinfection system for reduction of healthcare-associated pathogens. J. Microbiol. Immunol. Infect. 2019, 52, 487–493. [Google Scholar] [CrossRef]
- Ramos, C.C.; Roque, J.L.; Sarmiento, D.B.; Suarez, L.E.; Sunio, J.T.; Tabungar, K.I.; Tengco, G.S.; Rio, P.C.; Hilario, A.L. Use of ultraviolet-C in environmental sterilization in hospitals: A systematic review on efficacy and safety. Int. J. Health Sci. 2020, 14, 52. [Google Scholar]
- Sakudo, A.; Yagyu, Y.; Onodera, T. Disinfection and sterilization using plasma technology: Fundamentals and future perspectives for biological applications. Int. J. Mol. Sci. 2019, 20, 5216. [Google Scholar] [CrossRef]
- Rutala, W.A.; Weber, D.J. Disinfection, sterilization, and antisepsis: An overview. Am. J. Infect. Control 2019, 47, A3–A9. [Google Scholar] [CrossRef]
- UNCTAD. UN Launches Drive to Highlight Environmental Cost of Staying Fashionable. Available online: https://news.un.org/en/story/2019/03/1035161 (accessed on 15 May 2023).
- Jinia, A.J.; Sunbul, N.B.; Meert, C.A.; Miller, C.A.; Clarke, S.D.; Kearfott, K.J.; Matuszak, M.M.; Pozzi, S.A. Review of disinfection techniques for medical and personal protective equipment contaminated with SARS-CoV-2. IEEE Access 2020, 8, 111347–111354. [Google Scholar] [CrossRef]
- Rani, L. Disinfection protocols in dentistry-a review. J. Pharm. Sci. Res. 2016, 8, 558. [Google Scholar]
- Karcher Futuretech. Decontamination of Equipment and Clothing. Available online: https://www.karcher-futuretech.com/en/products/mobile-cbrn-decontamination/decontamination-of-equipment-and-clothing.html (accessed on 15 May 2023).
- Pi, S.; Liu, C.; Zhang, J.X.; Li, N.; Shen, J.J.; Guo, W.; Qin, L.; Zhao, J.; Zhang, S.D.; Wang, Z.Y. Durable rapid self-disinfection, reusable protective clothing based on the Ag-Pd@MoS2 nanozyme with enhanced triple-mode synergistic antibacterial effect. ACS Appl. Mater. Interfaces 2023, 15, 18032–18044. [Google Scholar] [CrossRef]
- Kim, D.; Kim, S.; Kang, D. Inactivation modeling of human enteric virus surrogates, MS2, Qβ, and ΦX174, in water using UVC-LEDs, a novel disinfecting system. Food Res. Int. 2017, 91, 115–123. [Google Scholar] [CrossRef] [PubMed]
- Lo, C.; Matsuura, R.; Iimura, K.; Wada, S.; Shinjo, A.; Benno, Y.; Nakagawa, M.; Takei, M.; Aida, Y. UVC disinfects SARS-CoV-2 by induction of viral genome damage without apparent effects on viral morphology and proteins. Sci. Rep. 2021, 11, 13804. [Google Scholar] [CrossRef]
- Buonanno, M.; Welch, D.; Shuryak, I.; Brenner, D.J. Far-UVC light (222nm) efficiently and safely inactivates airborne human coronaviruses. Sci. Rep. 2020, 10, 10285. [Google Scholar] [CrossRef]
- Lau, B.; Becher, D.; Hessling, M. High intensity violet light (405nm) inactivates coronaviruses in phosphate buffered saline (PBS) and on surfaces. Photonics 2021, 8, 414. [Google Scholar] [CrossRef]
- Weyersberg, L.; Klemens, E.; Buehler, J.; Vatter, P.; Hessling, M. UVC, UVB and UVA susceptibility of Phi6 and its suitability as a SARS-CoV-2 surrogate. AIMS Microbiol. 2022, 8, 278. [Google Scholar] [CrossRef]
- Trivellin, N.; Piva, F.; Fiorimonte, D.; Buffolo, M.; De Santi, C.; Orlandi, V.T.; Dughiero, F.; Meneghesso, G.; Zanoni, E.; Meneghini, M. UV-based technologies for SARS-CoV2 inactivation: Status and perspectives. Electronics 2021, 10, 1703. [Google Scholar] [CrossRef]
- Biasin, M.; Bianco, A.; Pareschi, G.; Cavalleri, A.; Cavatorta, C.; Fenizia, C.; Galli, P.; Lessio, L.; Lualdi, M.; Tombetti, E.; et al. UV-C irradiation is highly effective in inactivating SARS-CoV-2 replication. Sci. Rep. 2021, 11, 6260. [Google Scholar] [CrossRef]
- Chatterley, C.; Linden, K. Demonstration and evaluation of germicidal UV-LEDs for point-of-use water disinfection. J. Water Health 2010, 8, 479–486. [Google Scholar] [CrossRef]
- Qiu, X.; Lo, J.C.C.; Lee, S.W.R. Packaging of UV LED with a stacked silicon reflector for converged UV emission. In Proceedings of the 2017 International Conference on Electronics Packaging (ICEP), Yamagata, Japan, 19–22 April 2017. [Google Scholar]
- Photon Wave, Technology. Available online: http://www.photonwave.co.kr/technology/photon-wave-core-technology (accessed on 15 May 2023).
- Kragh, K.N.; Alhede, M.; Rybtke, M.; Stavnsberg, C.; Jensen, P.Ø.; Tolker-Nielsen, T.; Whiteley, M.; Bjarnsholt, T. The inoculation method could impact the outcome of microbiological experiments. Appl. Environ. Microbiol. 2018, 84, e02264-17. [Google Scholar] [CrossRef] [PubMed]
- GB 19082-2003; Technical Requirements for Single-Use Protective Clothing for Medical Use. Standards Press of China: Beijing, China, 2002.
- Qiu, X.; Lo, J.C.C.; Cheng, Y.J.; Xu, H.; Xu, Q.W.; Lee, S.W.R. Implementation and characterisation of a sterilisation module consisting of novel 265nm UVC LED packages. HKIE Trans. 2021, 28, 213–220. [Google Scholar] [CrossRef]
- Tessarolo, F.; Nollo, G.; Maniglio, D.; Rigoni, M.; Benedetti, L.; Helfer, F.; Corradi, I.; Rovati, L.; Ferrari, A.; Piccini, M.; et al. Testing surgical face masks in an emergency context: The experience of Italian laboratories during the COVID-19 pandemic crisis. Int. J. Environ. Res. Public Health 2021, 18, 1462. [Google Scholar] [CrossRef] [PubMed]
- Liu, Z.; Long, H.; Wang, Y.; Shen, C.; Chen, D. Antimicrobial nonwoven fabrics incorporated with levulinic acid and sodium dodecyl sulfate for use in the food industry. Foods 2022, 11, 2369. [Google Scholar] [CrossRef]
- GB 19082-2009; Technical Requirements for Single-Use Protective Clothing for Medical Use. Standards Press of China: Beijing, China, 2009.







| Driving current (mA) | 100 | 200 | 300 | 400 |
| Junction temperature increase (℃) | 14 | 28 | 42 | 55 |
| Position | Irradiance @ 350 mA ) | Normalized Irradiance |
|---|---|---|
| A | 94 | 92% |
| B | 94 | 92% |
| C | 92 | 90% |
| D | 93 | 91% |
| E | 102 | 100% |
| Comparison of Colony Number | Original Colony Number | ||
|---|---|---|---|
| Control specimen | ![]() | ![]() | ![]() |
| UVC-treated specimen | ![]() | ![]() | ![]() |
| Species | Disinfection Rate (%) | Standard Deviation |
|---|---|---|
| Escherichia coli (E. coli) | 99.99 (3 trials) | 0 |
| Staphylococcus aureus (S. aureus) | 99.99 (3 trials) | 0 |
| Pseudomonas aeruginosa | 99.99 (3 trials) | 0 |
| Influenza A virus (H1N1) | 99.94, 99.92, 99.9 | 0.02 |
| Human enterovirus 71 (EV71) | 99.83, 99.79, 99.57 | 0.14 |
| Klebsiella pneumoniae | 99 (3 trials) | 0 |
| Salmonella typhimurium | 99 (3 trials) | 0 |
| Legionella pneumonia | 99 (3 trials) | 0 |
| Engineering Parameters | |
|---|---|
| Irradiance wavelength | 265 nm |
| Number of the 265 nm LED package | 56 |
| Working current | 200 mA |
| Cloth capacity for one disinfection cycle | 1 or 2 protective clothes |
| Number of the LED module | 14 |
| Dimension | 550 mm × 530 mm × 1840 mm |
| Power | 60 W |
| Disinfection time | 1 min |
| UVC Disinfection Time (min) | VFE (%) | Standard Deviation of VFE | BFE (%) | Standard Deviation of BFE |
|---|---|---|---|---|
| 0 | 99.9 | 0 | 99.9 | 0 |
| 1 | 99.9 | 0 | 99.9 | 0 |
| 2 | 99.9 | 0 | 99.9 | 0 |
| 3 | 99.9 | 0 | 99.9 | 0 |
| 4 | 99.9 | 0 | 99.9 | 0 |
| 5 | 99.9 | 0 | 99.9 | 0 |
| 10 | 99.9 | 0 | 99.9 | 0 |
| 20 | 99.9 | 0 | 99.9 | 0 |
| 30 | 99.9 | 0 | 99.9 | 0 |
| 60 | 99.9 | 0 | 99.9 | 0 |
Disclaimer/Publisher’s Note: The statements, opinions and data contained in all publications are solely those of the individual author(s) and contributor(s) and not of MDPI and/or the editor(s). MDPI and/or the editor(s) disclaim responsibility for any injury to people or property resulting from any ideas, methods, instructions or products referred to in the content. |
© 2025 by the authors. Licensee MDPI, Basel, Switzerland. This article is an open access article distributed under the terms and conditions of the Creative Commons Attribution (CC BY) license (https://creativecommons.org/licenses/by/4.0/).
Share and Cite
Qiu, X.; Lo, J.C.C.; Cheng, Y.; Xu, H.; Xu, Q.; Lee, S.-W.R. An Efficient Contamination-Reducing Closet for Reusing Protective Clothing. Inventions 2025, 10, 18. https://doi.org/10.3390/inventions10010018
Qiu X, Lo JCC, Cheng Y, Xu H, Xu Q, Lee S-WR. An Efficient Contamination-Reducing Closet for Reusing Protective Clothing. Inventions. 2025; 10(1):18. https://doi.org/10.3390/inventions10010018
Chicago/Turabian StyleQiu, Xing, Jeffery C. C. Lo, Yuanjie Cheng, Hua Xu, Qianwen Xu, and Shi-Wei Ricky Lee. 2025. "An Efficient Contamination-Reducing Closet for Reusing Protective Clothing" Inventions 10, no. 1: 18. https://doi.org/10.3390/inventions10010018
APA StyleQiu, X., Lo, J. C. C., Cheng, Y., Xu, H., Xu, Q., & Lee, S.-W. R. (2025). An Efficient Contamination-Reducing Closet for Reusing Protective Clothing. Inventions, 10(1), 18. https://doi.org/10.3390/inventions10010018